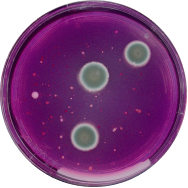
ISO 21527-2008

Applications
Automate your food & water QC testing with ISO verified AI-models
Go from manual to automated QC workflows with AI models trained on 50M+ microbiological experiments and built for ISO methods.
Methods
We support all plate-based methods. Here's a selection of the most common ones.